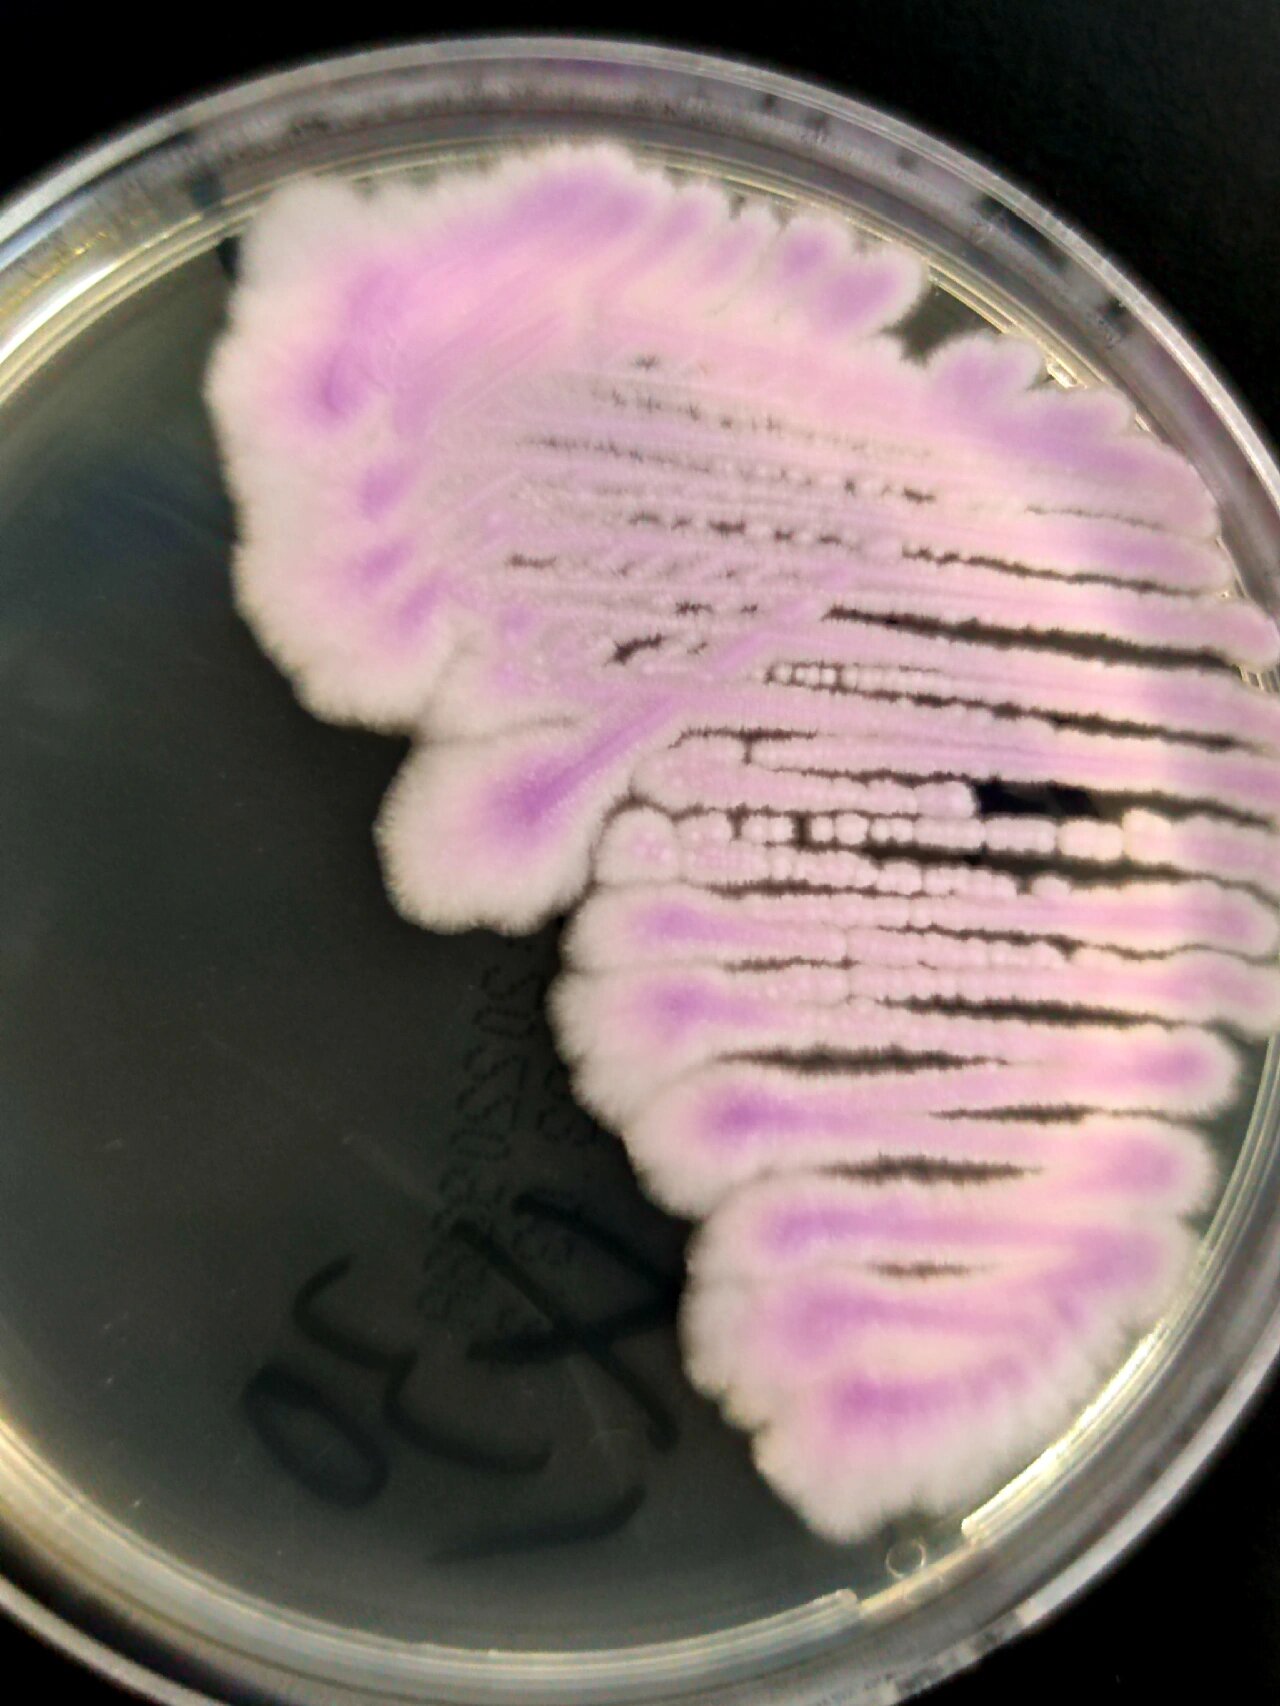
微生物之《克柔念珠菌》
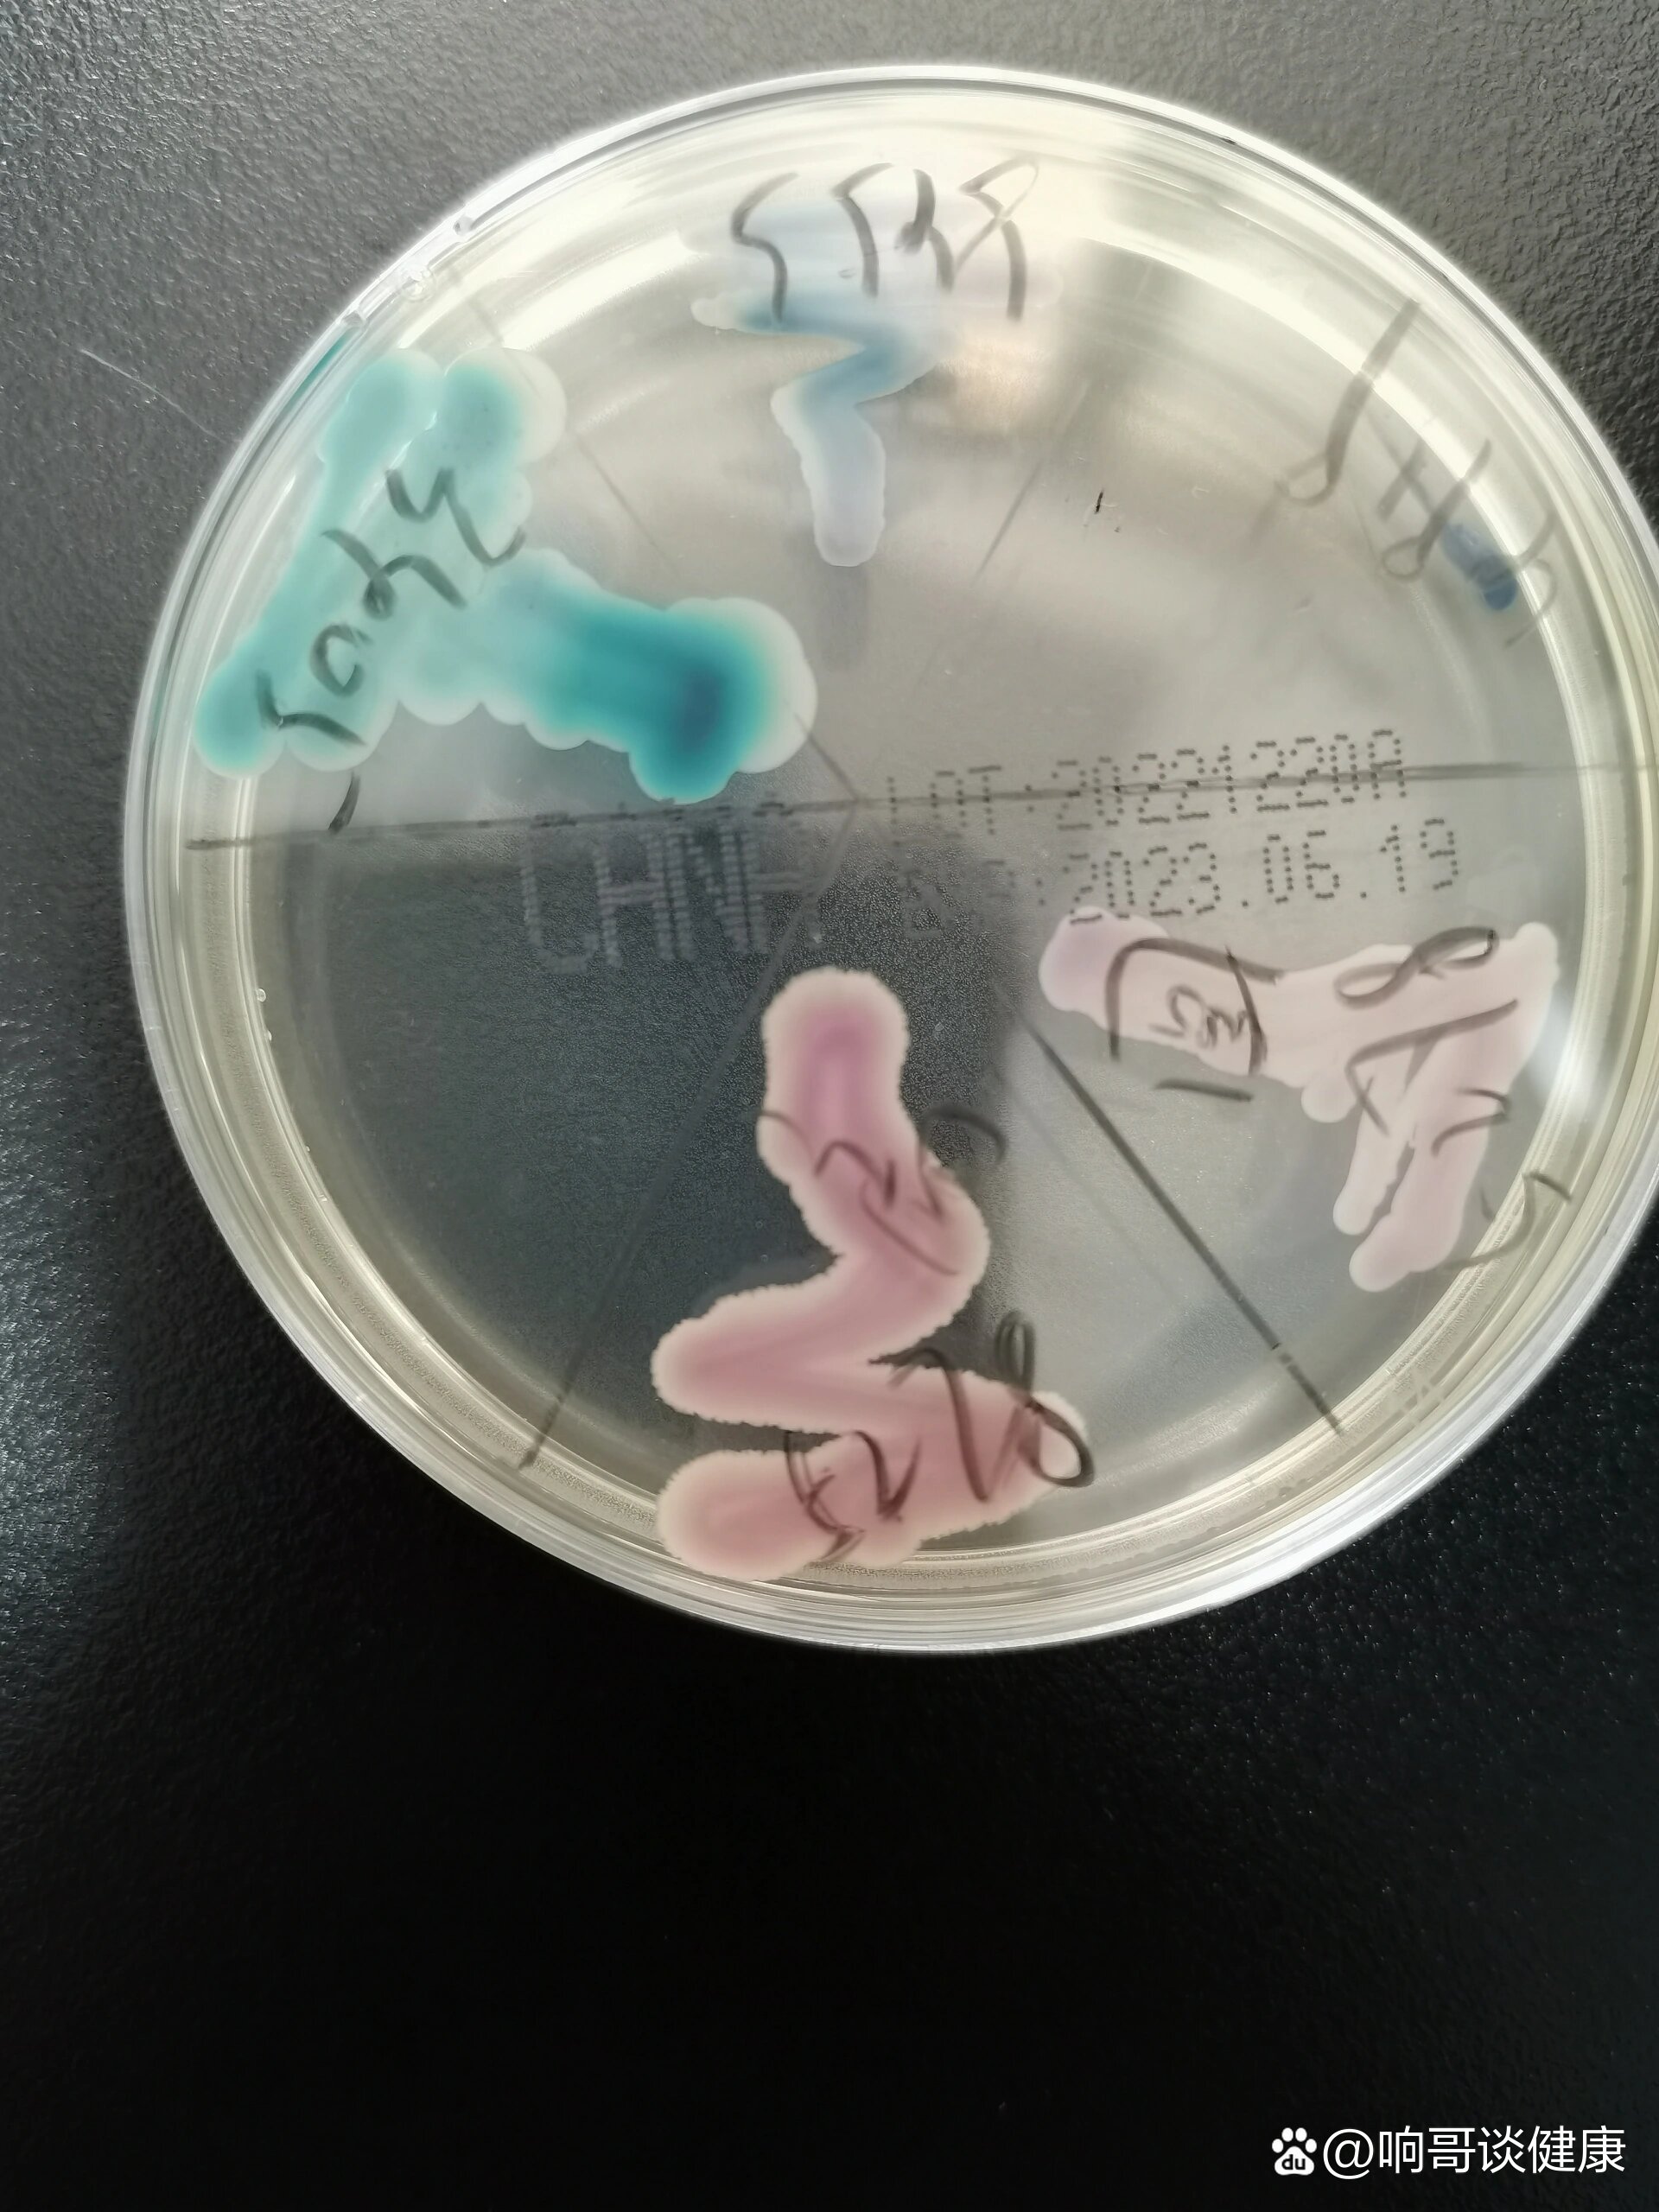
笔记22:克柔念珠菌吐温80玉米培养镜下形态
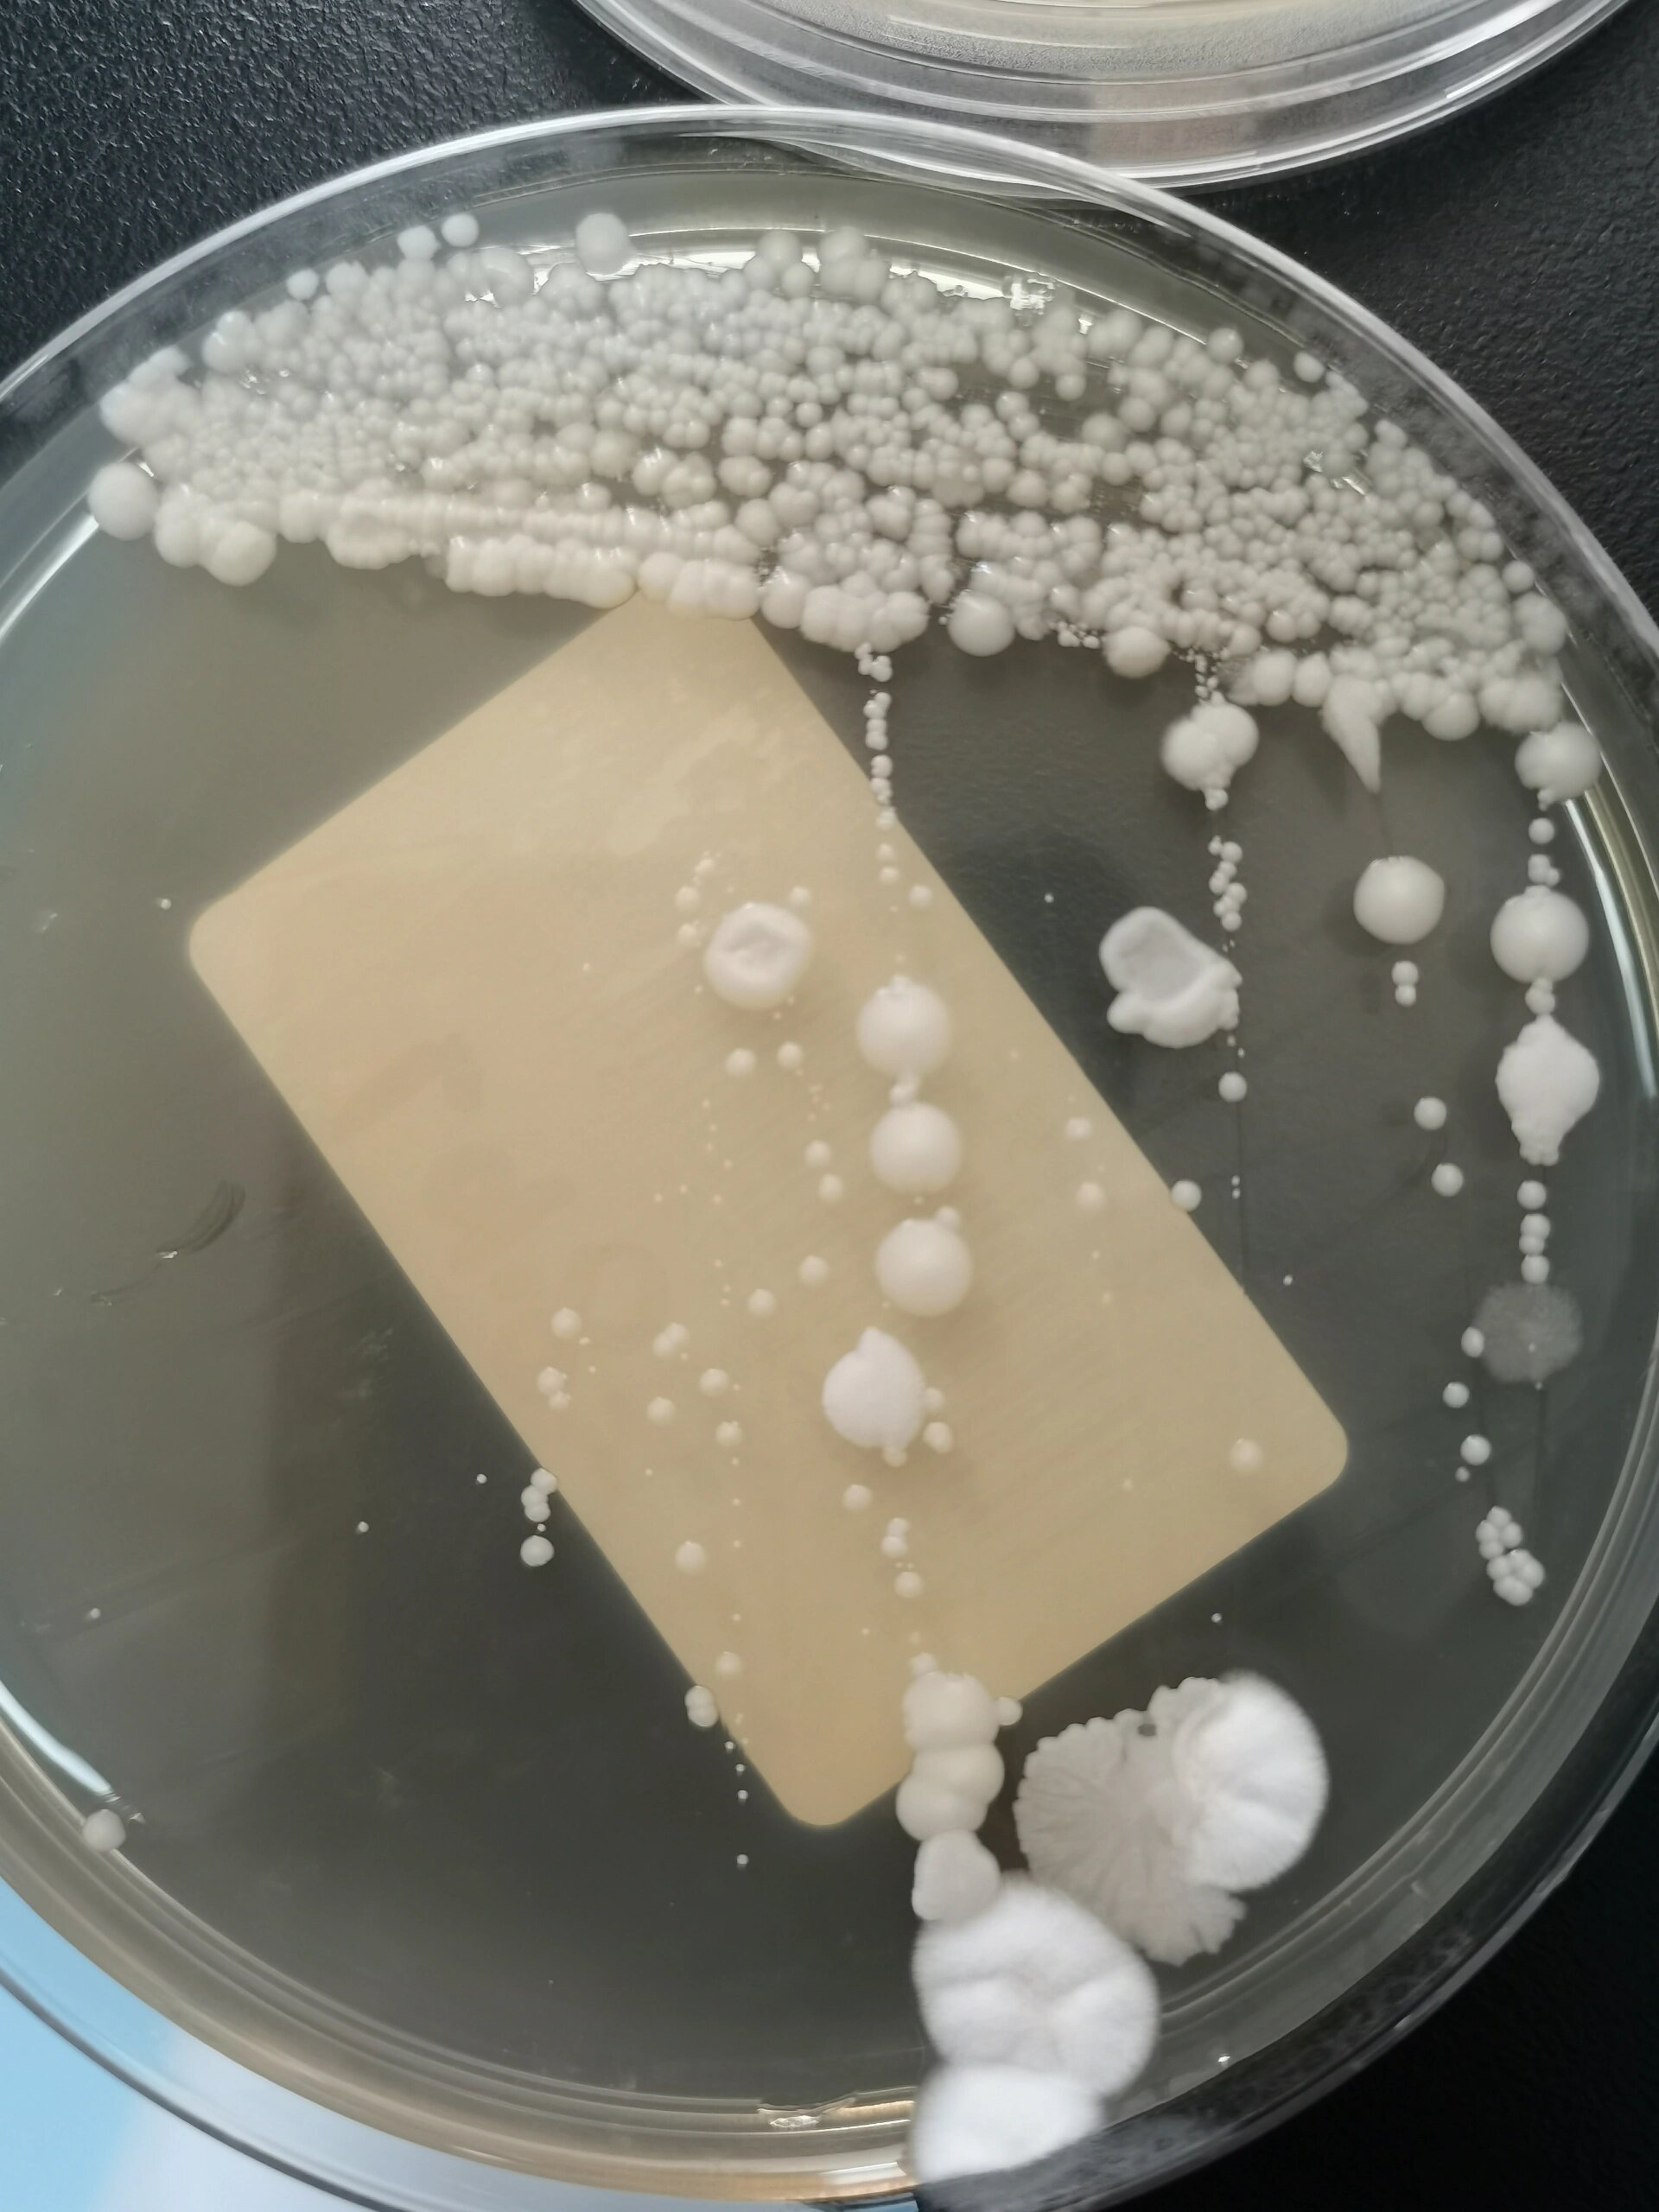
笔记22:克柔念珠菌吐温80玉米培养镜下形态
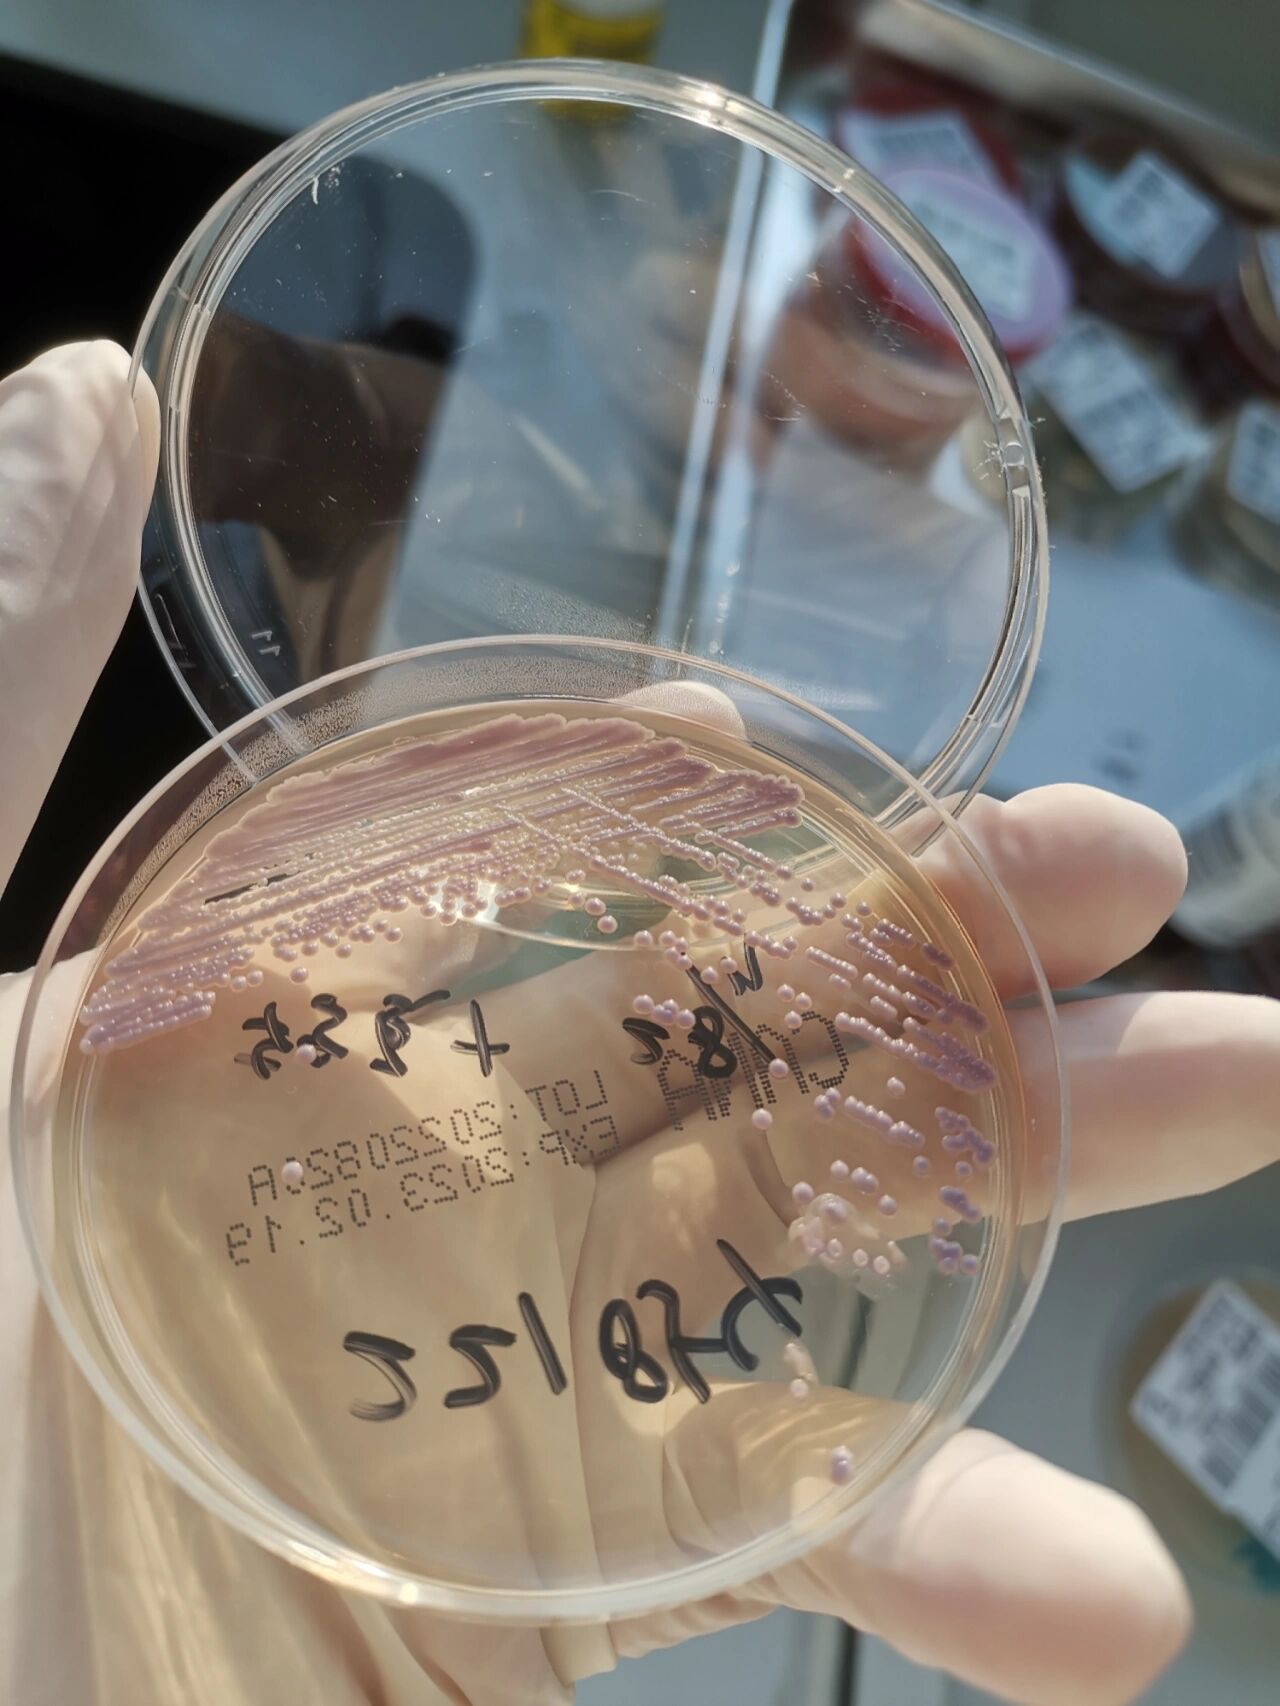
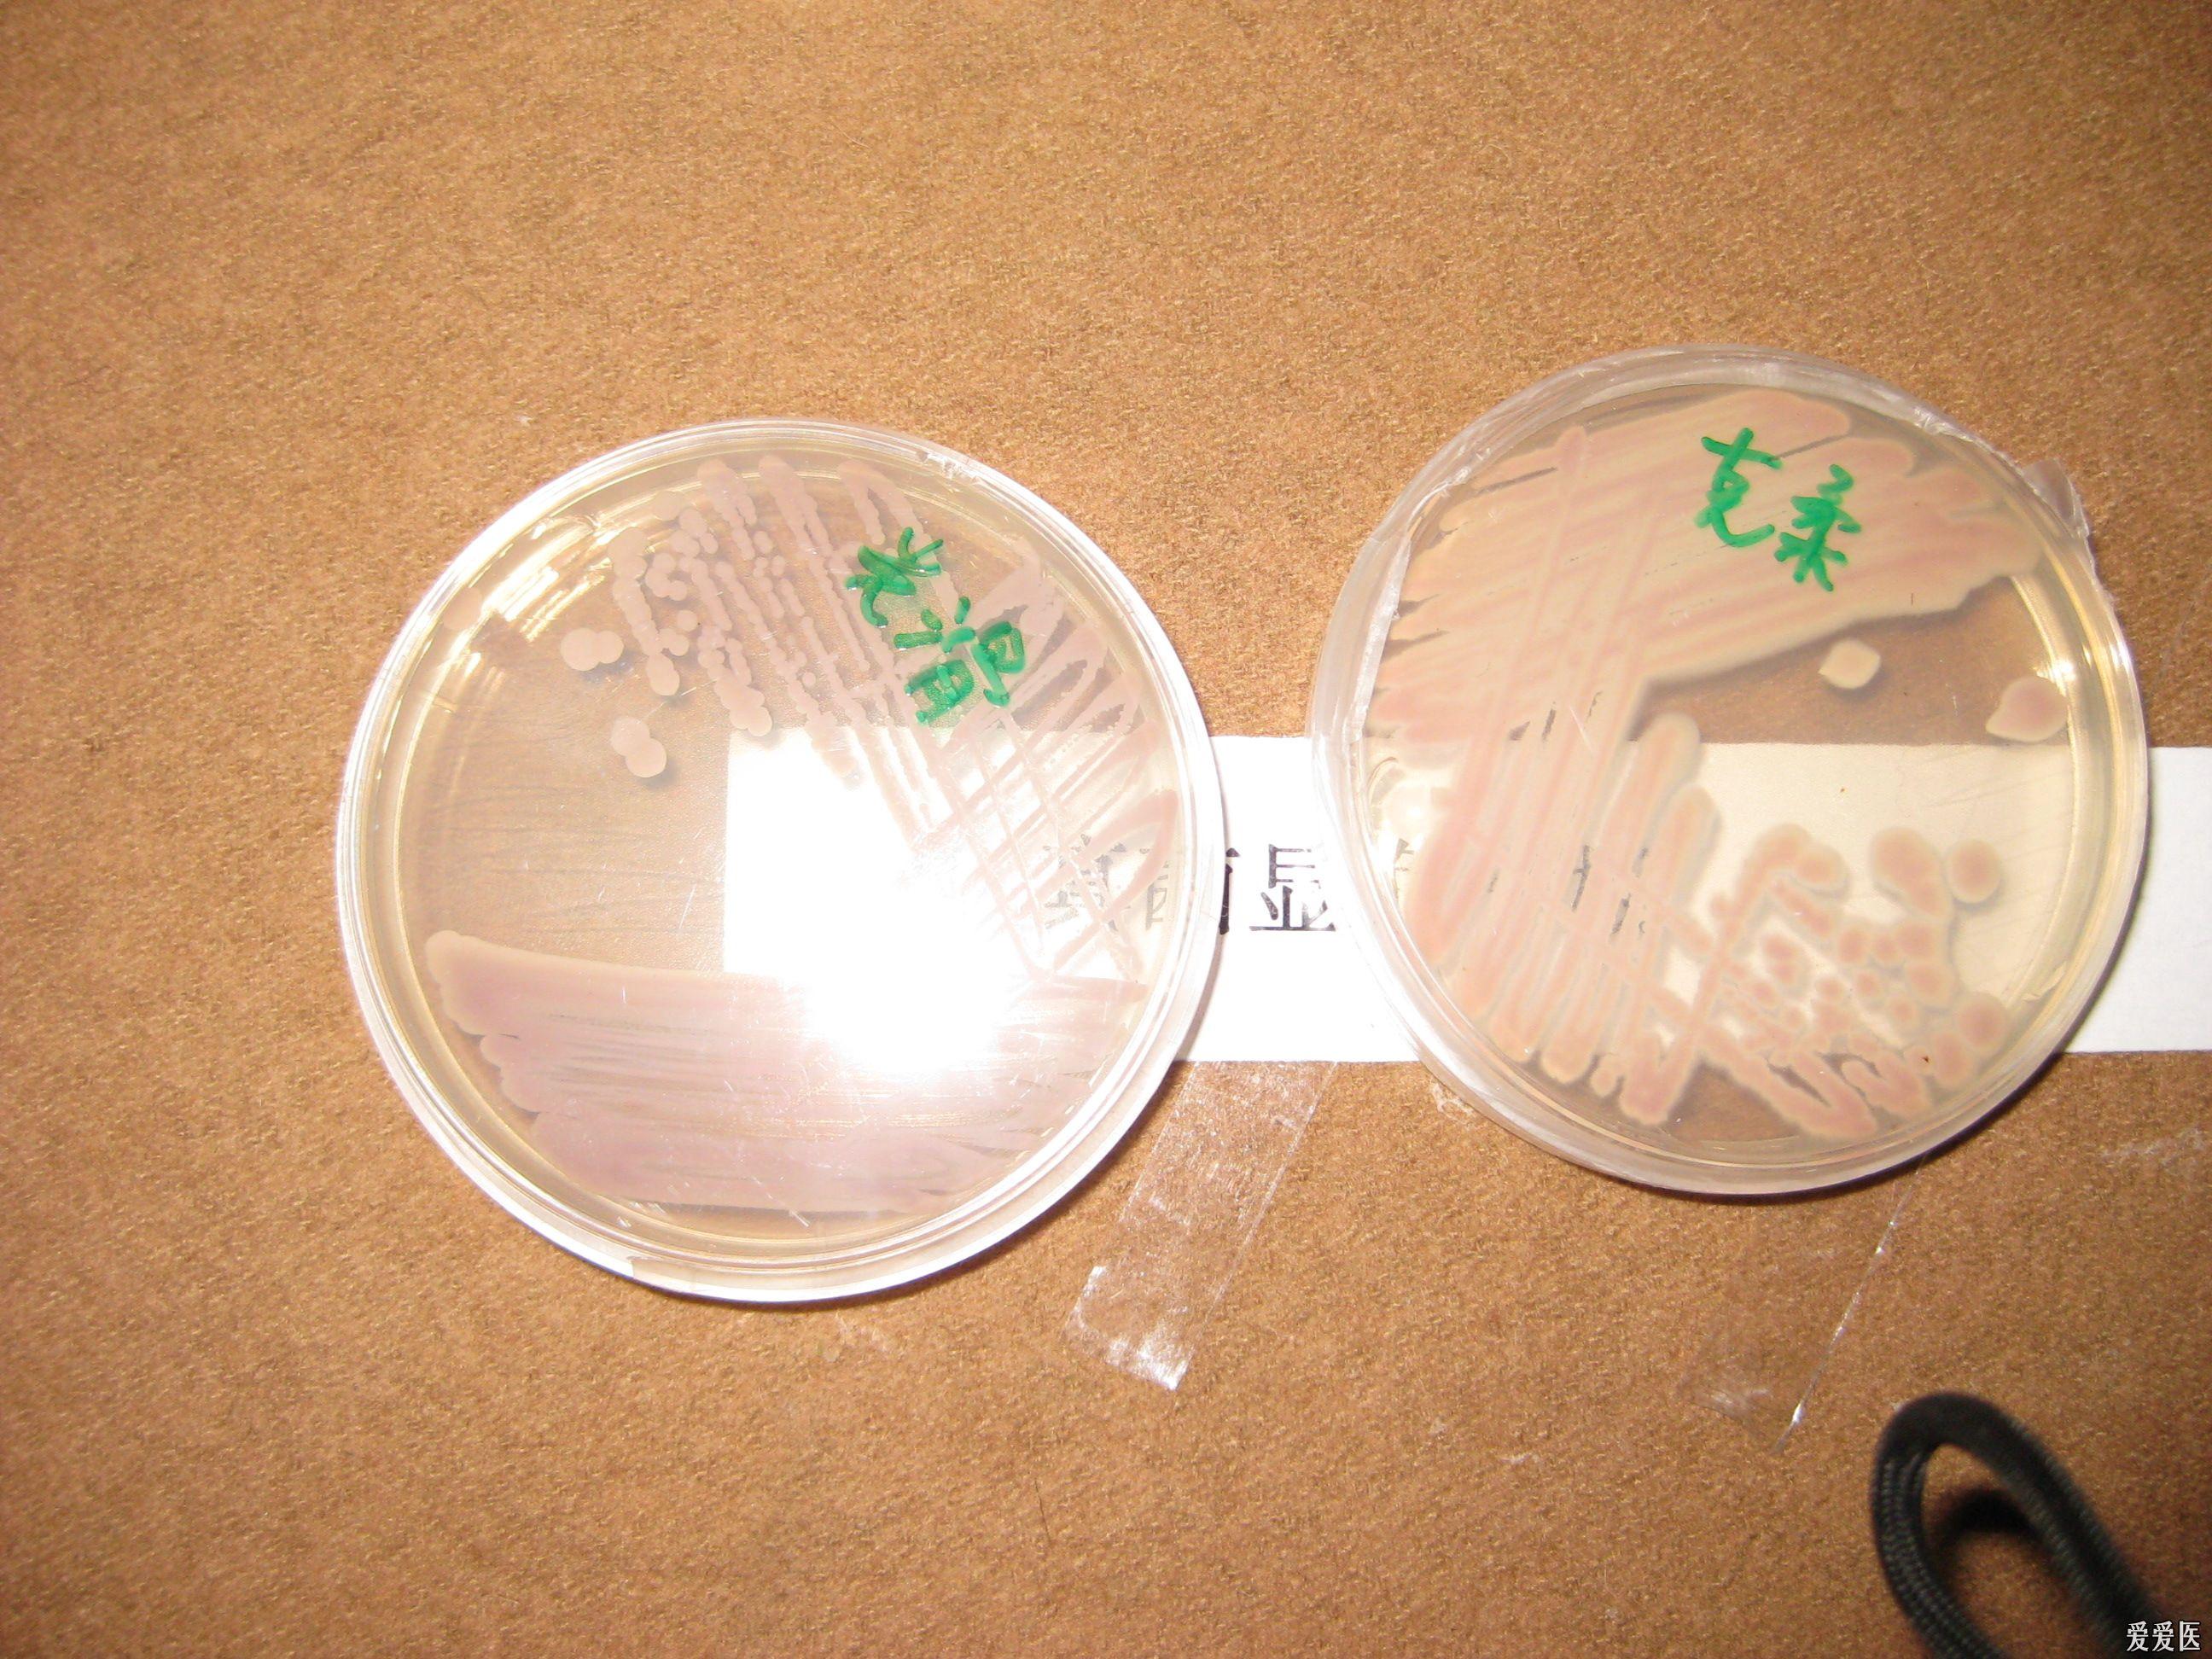
光滑与克柔氏念珠菌在念珠菌显色平板上的图片

克柔念珠菌形态

微生物之《克柔念珠菌》
图片尺寸1280x1706
笔记22:克柔念珠菌吐温80玉米培养镜下形态
图片尺寸1920x2560
笔记22:克柔念珠菌吐温80玉米培养镜下形态
图片尺寸1920x2560
克柔念珠菌呈革兰阳性,假菌丝对称分枝,有细长的芽生孢子,细胞形态为
图片尺寸1225x1589
临床知识
图片尺寸1080x1070
临床知识
图片尺寸1048x1056
克柔,好美的名字#念珠菌
图片尺寸690x920
克柔念珠菌,作为一种真菌病原体,其尿液标本通常呈现出特定的形态特征
图片尺寸1080x1167
临床知识
图片尺寸1049x1044
克柔,好美的名字#念珠菌
图片尺寸690x920 图片尺寸1280x1706
图片尺寸1280x1706 图片尺寸1280x1707
图片尺寸1280x1707
分享几张念珠菌显微镜下的形态吧
图片尺寸1080x810 图片尺寸540x719
图片尺寸540x719
光滑与克柔氏念珠菌在念珠菌显色平板上的图片
图片尺寸2592x1944
各种念珠菌菌落形态图片欣赏
图片尺寸1024x768
63301光滑念珠菌atcc 15126克柔假丝酵母菌
图片尺寸2000x1886
念珠菌家族🌈🌈🌈 接上篇,是各个念珠菌革兰染色后的镜下形态
图片尺寸1280x1705
科学家喊话应该立即停止研究!
图片尺寸800x1067
显微镜下的念珠菌世界
图片尺寸720x960






 图片尺寸1280x1706
图片尺寸1280x1706 图片尺寸1280x1707
图片尺寸1280x1707 图片尺寸540x719
图片尺寸540x719

图片尺寸1280x1706
图片尺寸1280x1706 图片尺寸1280x1707
图片尺寸1280x1707 图片尺寸540x719
图片尺寸540x719